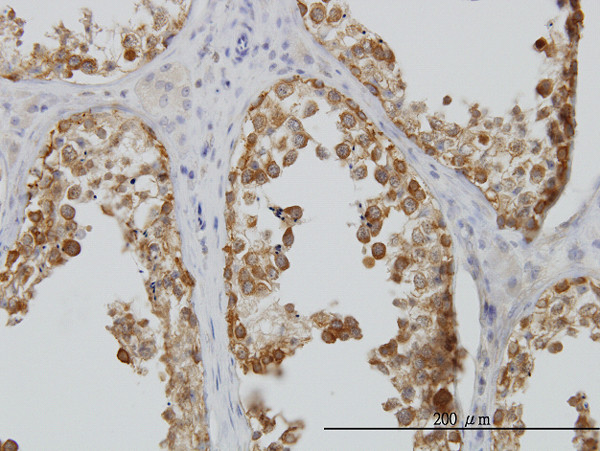
DDX6 Antibody in Immunohistochemistry (Paraffin) (IHC (P))

Search
Abnova
DDX6 Monoclonal Antibody (3D2)
{{$productOrderCtrl.translations['antibody.pdp.commerceCard.promotion.promotions']}}
{{$productOrderCtrl.translations['antibody.pdp.commerceCard.promotion.viewpromo']}}
{{$productOrderCtrl.translations['antibody.pdp.commerceCard.promotion.promocode']}}: {{promo.promoCode}} {{promo.promoTitle}} {{promo.promoDescription}}. {{$productOrderCtrl.translations['antibody.pdp.commerceCard.promotion.learnmore']}}
产品信息
H00001656-M01
种属反应
宿主/亚型
分类
类型
克隆号
抗原
偶联物
形式
浓度
规格
纯化类型
保存液
内含物
保存条件
运输条件
产品详细信息
Sequence of this protein is as follows: MSTARTENPV IMGLSSQNGQ LRGPVKPTGG PGGGGTQTQQ QMNQLKNTNT INNGTQQQAQ SMTTTIKPGD DWKKTLKLPP KDLRIKTSDV TSTKGNEFED YCLKRELLMG IFEMGWEKPS PIQEESIPIA LSGRDILARA KNGTGKSGAY LIPLLERLDL KKDNIQAMVI VPTRELALQV SQICIQVSKH MGGAKVMATT GGTNLRDDIM RLDDTVHVVI ATPGRILDLI KKGVAKVDHV QMIVLDEADK LLSQDFVQIM EDIILTLPKN RQILLYSATF PLSVQKFMNS HLQKPYEINL MEELTLKGVT QYYAYVTERQ KVHCLNTLFS RLQINQSIIF CNSSQRVELL AKKISQLGYS CFYIHAKMRQ EHRNRVFHDF RNGLCRNLVC TDLFTRGIDI QAVNVVINFD FPKLAETYLH RIGRSGRFGH LGLAINLITY DDRFNLKSIE EQLGTEIKPI PSNIDKSLYV AEYHSEPVED EKP
靶标信息
This gene encodes a member of the DEAD box protein family. The protein is an RNA helicase found in P-bodies and stress granules, and functions in translation suppression and mRNA degradation. It is required for microRNA-induced gene silencing.
仅用于科研。不用于诊断过程。未经明确授权不得转售。
篇参考文献 (0)
生物信息学
蛋白别名: ATP-dependent RNA helicase p54; DEAD (Asp-Glu-Ala-Asp) box helicase 6; DEAD (Asp-Glu-Ala-Asp) box polypeptide 6; DEAD box protein 6; DEAD box-6; DEAD-box protein 6; DEAD/H (Asp-Glu-Ala-Asp/His) box polypeptide 6 (RNA helicase, 54kD); Oncogene RCK; Probable ATP-dependent RNA helicase DDX6; unnamed protein product
基因别名: DDX6; HLR2; IDDILF; P54; RCK; Rck/p54
UniProt ID: (Human) P26196
Entrez Gene ID: (Human) 1656